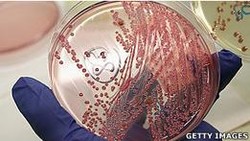
Kemenkes Perintahkan Pelabuhan Cermati Penumpang dari Eropa yang Diare

detikNews
Imigrasi Belum Temukan Indikasi Nunun Miliki Paspor Ganda
Ditjen Imigrasi Kemenkum HAM mendeteksi Nunun Nurbaeti melakukan perjalanan ke Kamboja dua bulan sebelum paspornya dicabut. Imigrasi belum menemukan data Nunun memiliki paspor ganda.
Selasa, 07 Jun 2011 13:10 WIB

-luar.jpg?w=250&q=90)